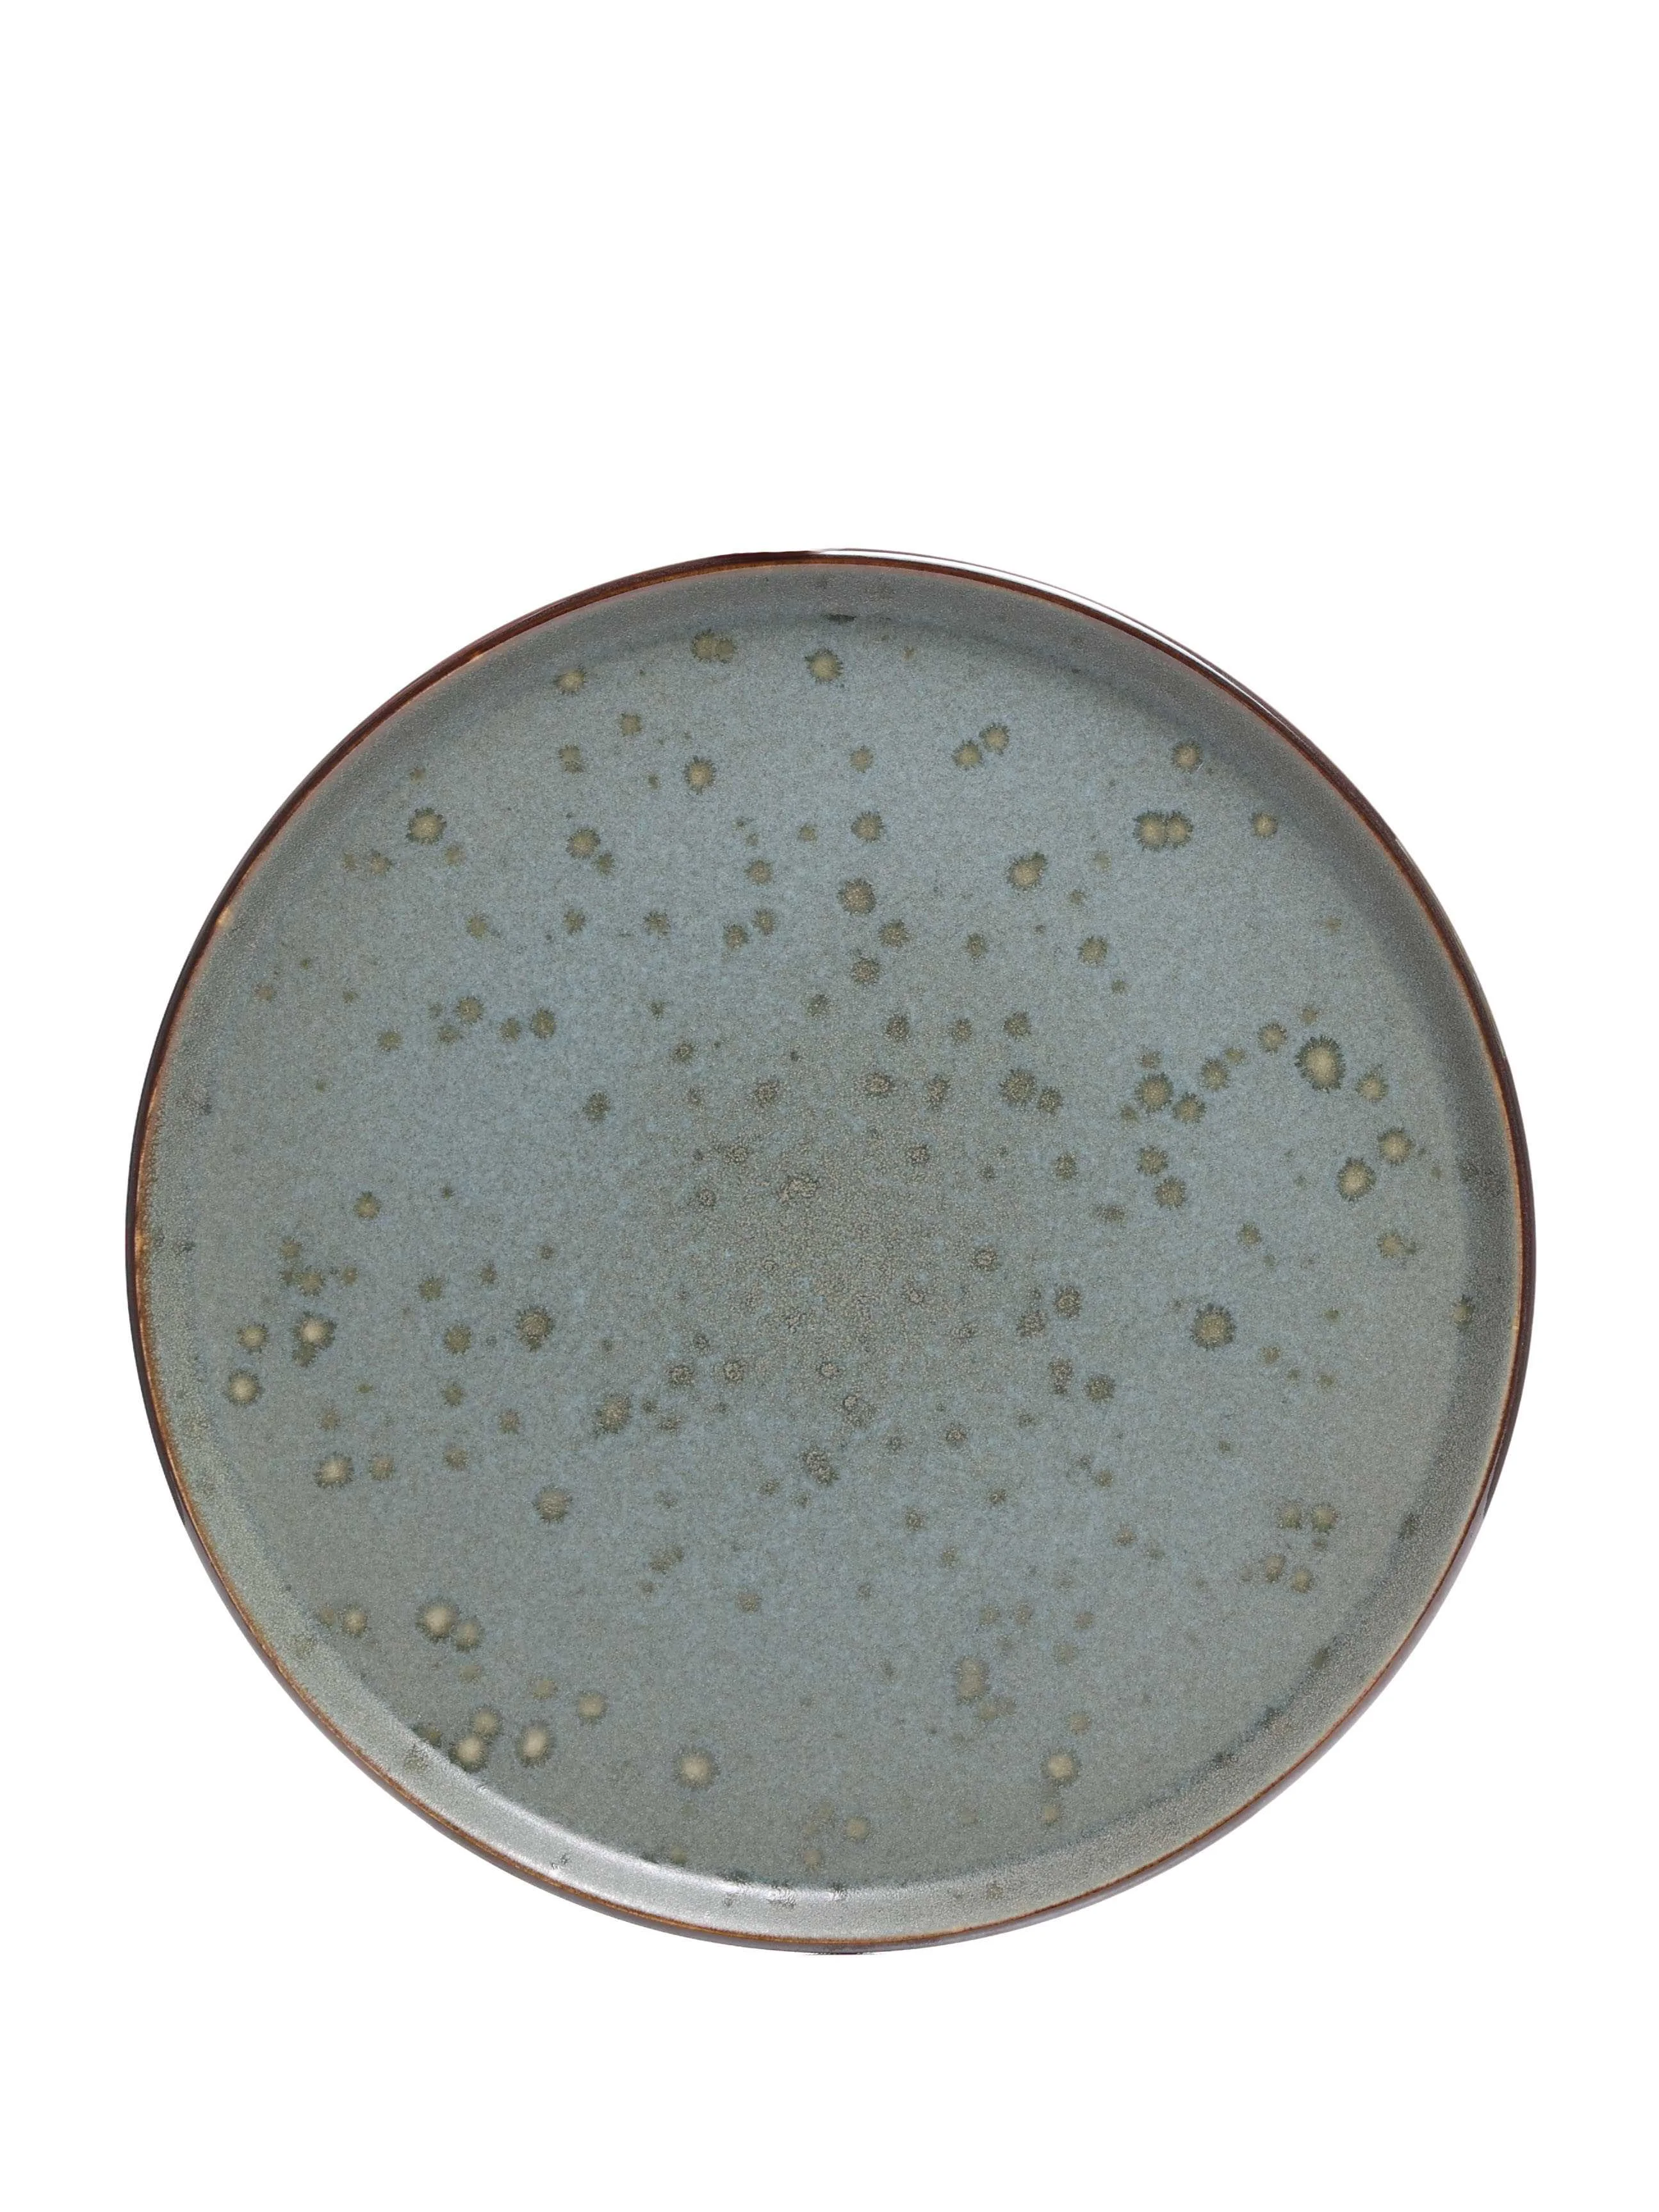

Your cart
There are no more items in your cart
Color: green

Choose color

Check In-Store Availability
Dessert Plate
• Modern design — a perfect detail for everyday serving
• Material: Ceramic
• Suitable for home use as well as cafés and restaurants
• Size: 21 cm
- Brand
- Koopman
- Brand's Country
- Netherlands
- Composition
- Ceramic
- Detailed Composition
- Pottery
- Color
- green
- Dimensions
- 21CM/სმ
- Category
- TABLEWARE & KITCHEN
- Subcategory
- PLATES
- Type
- DESSERT PLATE